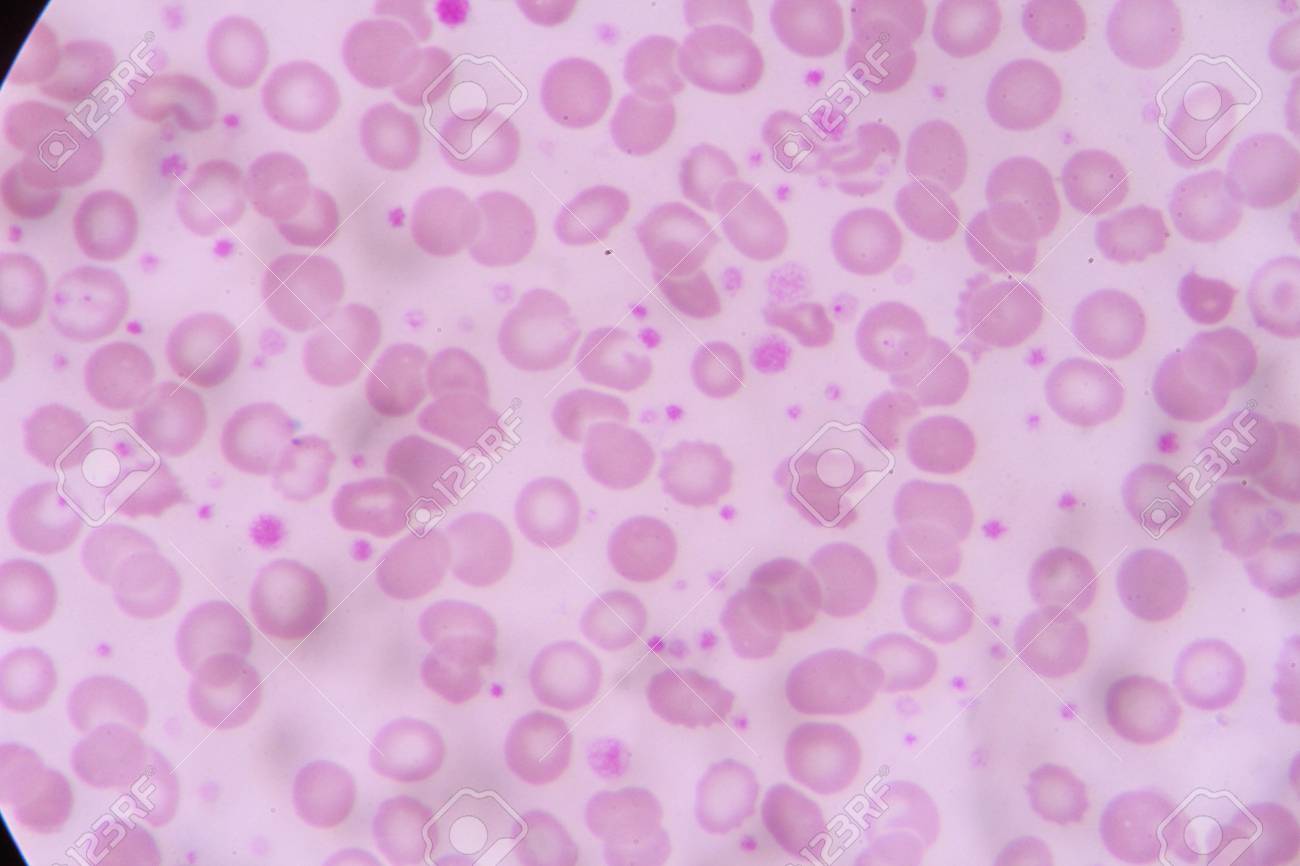
etiam-dictum-ipsum-a-felis

Download
Close
Автор:
id:
Ключевые слова:
abnormal, acute, anemia, blood, bone, burr cell, cbc, cell, cells, crenated cell, disease, eosinophil, health, hematology, hypochromia, increase, laboratory, leukemia, lymphocyte, marrow, medical, medicine, microscope, monocyte, neutrophils, ovalocyte, platelet, poikilocytosis, red, rouleaux formation, schistocyte, sickle cell, slides, smear, spherocyte, stomatocyte, target cell, tear drop, white,





